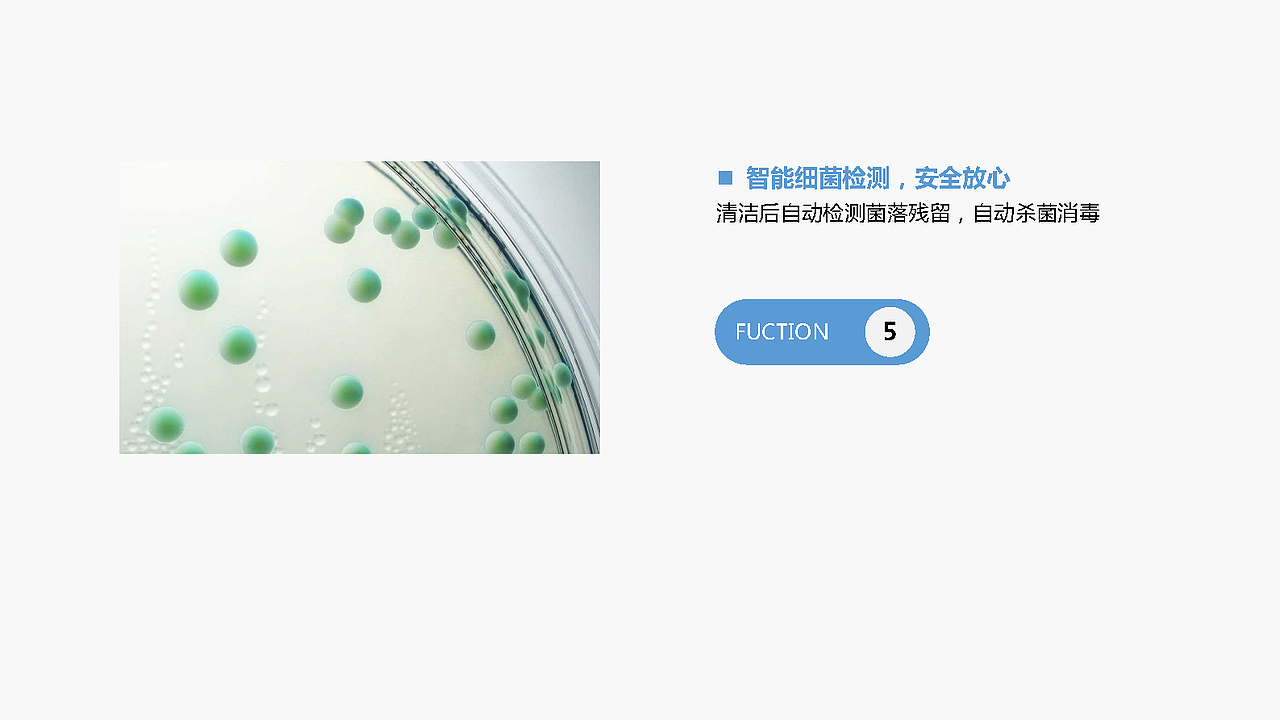
LIGHT 轻生活洗碗机

LIGHT 轻生活洗碗机
南京/设计爱好者/5年前/465浏览
版权
LIGHT 轻生活洗碗机
小组成员:
陈雨莲 李潇晗
0
Report
声明
4
Share
相关推荐
in to comment
Add emoji
喜欢TA的作品吗?喜欢就快来夸夸TA吧!
You may like
相关收藏夹
Log in
推荐Log in and synchronize recommended records
4Log in and add to My Favorites
评论Log in and comment your thoughts
分享Share